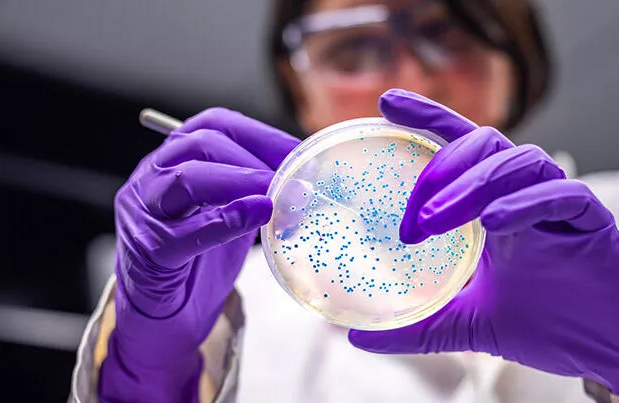

| Hisse | Fiyat | Değişim(%) | Piyasa Değeri |
|---|---|---|---|
| AKBNK | 70,90 | -3,67 | 368.680.000.000,00 |
| ALBRK | 8,22 | -0,12 | 20.550.000.000,00 |
| GARAN | 129,60 | -4,07 | 544.320.000.000,00 |
| HALKB | 38,80 | 0,15 | 278.769.388.029,60 |
| ICBCT | 14,76 | 0,00 | 12.693.600.000,00 |
| ISCTR | 13,54 | -2,94 | 338.499.593.800,00 |
| SKBNK | 10,66 | -1,57 | 26.650.000.000,00 |
| TSKB | 12,04 | -2,75 | 33.712.000.000,00 |
| VAKBN | 30,86 | -4,87 | 306.005.338.199,78 |
| YKBNK | 33,64 | -3,28 | 284.158.805.193,76 |
E-posta listemize kayıt olun, en son haberler adresinize gelsin.

Salgının başından beri gündemden düşmeyen Wuhan'daki Viroloji laboratuvarı yeni bir rapor ile yeniden tartışmaların odağında.
Hürriyet'teki habere göre; Temsilciler Meclisi Dış İlişkiler Komitesi'ndeki Cumhuriyetçileri tarafından hazırlanan rapor, salgının bu laboratuvardan sızdığı iddiasını yineledi ve bu sefer kesin bir tarih de verdi.
İngiliz Daily Mail gazetesinde yer alan habere göre, virüs laboratuvardan 12 Eylül 2019'dan önce kaçtı ve kentte yayılmaya başladı.
Açık kaynak verilerine bakıldığında bu tarihten sonra kentteki hastane yatışlarının artış gösterdiğinin altını çizen rapor, laboratuvarın veri tabanının internetten kaldırılması da dikkat çekiyor.
Geçtiğimiz haftalarda ise Çin'in korona virüs belgeleri sızmıştı. ABD Dışişleri Bakanlığı tarafından elde edilen belgelere dayandırılan haberlere göre, Çinli bilim adamları son altı yıldır korona virüs dahil biyolojik ve genetik silahlar üzerinde araştırmalar yürütüyor.
Aynı haberlere göre, 2015'ten beri SARS korona virüslerinin askeri potansiyelini değerlendiren Peki yönetimi bu projeyi olası bir 'Üçüncü Dünya Savaşı' senaryosu için hazır tutuyor.
Söz konusu belgelerde bu proje bir savaş durumunda 'zaferin temel silahı' olarak adlandırılıyor ve detaylı incelemeler sunuyor. Belgelerde Üçüncü Dünya Savaşı'nın beklenenin aksine kimyasal ve nükleer silahlar ile değil, biyolojik silahlar ile yapılacağı tezi yer alıyor.
ABD tarafından Japonya'nın Hiroşima ve Nagazaki kentlerine atılan iki atom bombasına atıfta bulunan belgelerde biyolojik silahların yeni bir dünya savaşında 'zafer için temel silah' olacağının altı çiziliyor.
The Australian gazetesinin haberinde ise Halk Kurtuluş Ordusu'nda görev alan bilim adamlarının hazırladığı dosya, hastalıkların 'daha önce hiç görülmemiş bir şekilde' silah yapmak için manipüle edilmesini incelediğini iddiası yer alıyor.
Belgelerde biyolojik silahların maksimum etkiyi göstermesi için gereken koşullar da özetleniyor. Belgelerde 'biyolojik saldırı gece veya şafak vakti sabit rüzgar yönü olduğu zamanda yapılmalı' ifadesi yer aşıyor.
CDC’nin Delta varyantına ilişkin iç raporu ortaya çıktı
Korona ile mücadelede yeni dönem! Aşı olana indirim
Finansingundemi.com’da yer alan bilgi, yorum ve tavsiyeleri yatırım danışmanlığı kapsamında değildir. Yatırım danışmanlığı hizmeti; aracı kurumlar, portföy yönetim şirketleri, mevduat kabul etmeyen bankalar ile müşteri arasında imzalanacak yatırım danışmanlığı sözleşmesi çerçevesinde sunulmaktadır. Burada yer alan yorum ve tavsiyeler, yorum ve tavsiyede bulunanların kişisel görüşlerine dayanmaktadır. Bu görüşler mali durumunuz ile risk ve getiri tercihlerinize uygun olmayabilir. Bu nedenle, sadece burada yer alan bilgilere dayanılarak yatırım kararı verilmesi beklentilerinize uygun sonuçlar doğurmayabilir. Burada yer alan bilgiler, güvenilir olduğuna inanılan halka açık kaynaklardan elde edilmiş olup bu kaynaklardaki bilgilerin hata ve eksikliğinden ve ticari amaçlı işlemlerde kullanılmasından doğabilecek zararlardan www.finansingundemi.com ve yöneticileri hiçbir şekilde sorumluluk kabul etmemektedir. Burada yer alan görüş ve düşüncelerin www.finansingundemi.com ve yönetimi için hiçbir bağlayıcılığı yoktur. BİST isim ve logosu “koruma marka belgesi” altında korunmakta olup izinsiz kullanılamaz, iktibas edilemez, değiştirilemez. BİST ismi altında açıklanan tüm bilgilerin telif hakları tamamen BİST’e ait olup, tekrar yayınlanamaz.